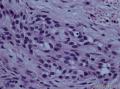
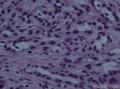
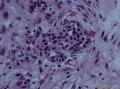

| 图片: | |
|---|---|
| 名称: | |
| 描述: | |
- 驻京部队252次读片会-304医院供片-5
免疫组化结果:
阳性Vim(+), CK(++), EMA (+), CK5/6(++), CK7(++), CK19(++), NSE (+), CD56 (+), CD99(++)。
阴性标记物:CK8/18、CK20、CA125、TTF-1、Villin、CDX-2、Moc31、GCDFP-15、BcA225、 CD34、CR、MC、WT-1
病理诊断:
(右胫骨中段)破碎的肿瘤组织由编织样排列的纤维组织与低立方上皮腺管组织构成,腺样结构多呈簇状分布。符合长骨釉质瘤,伴神经内分泌分化。
长骨釉质瘤
¡ 流行病学:占骨原发肿瘤的0.4%,可发生于3-86岁,中位年龄25-35岁。
¡ 发病部位:多发生于胫骨(近骺端骨干),尤其中下1/3处,占85%-90%。近10%伴有同侧腓骨的单个或多个病变。偶尔有其他发病部位的报道,如股骨、尺骨、锁骨和肋骨等。
¡ 影像学特点:骨干皮质内境界不清楚的溶骨性改变,以囊性、膨胀性为主,有时多房样呈“肥皂泡样”改变(沿长轴扩展)。病变周围有不同程度的硬化缘。骨皮质可增生、硬化,也可以骨质溶解,呈侵蚀性或浸润性破坏,甚至表现出骨膜反应并软组织肿块及远处转移等恶性特征。
¡ 经典釉质瘤组织病理学:由不同比例的上皮性和骨纤维成分构成。按上皮细胞形态分4型
Ø 基底细胞样
Ø 腺管状
Ø 梭形细胞型
Ø 鳞状细胞型
¡ 骨性纤维结构不良型釉质瘤 (OFD样釉质瘤)
¡ 免疫组化:纤维组织Vim阳性。上皮细胞同时表达CK、EMA、Vim。(CK7、CK19、CK5/6阳性,CK8/18阴性)
¡ 鉴别诊断:
Ø 转移癌
Ø 纤维结构不良
Ø 骨性纤维结构不良
Ø 滑膜肉瘤
Ø 其他骨内原发性梭形细胞肿瘤
¡ 组织起源:
Ø 上皮起源
Ø 间叶-上皮转化来源
Ø 神经嵴神经管来源
Ø 多分化潜能的干细胞来源
¡ 遗传学特点:染色体数目异常,主要是染色体7、8、12和19的扩增。
¡ 治疗:手术治疗,外科边界要广泛切除,对放、化疗不敏感。
¡ 预后:低度恶性,非根治手术易复发。可转移
¡
影响预后因素:性别、年龄、病程、初诊时的症状、肿瘤的鳞状细胞分化及上皮与纤维间质的比例等。
-
xionghanzhen 离线
- 帖子:11
- 粉蓝豆:19
- 经验:112
- 注册时间:2010-09-20
- 加关注 | 发消息
免疫组化结果:
阳性Vim(+), CK(++), EMA (+), CK5/6(++), CK7(++), CK19(++), NSE (+), CD56 (+), CD99(++)。
阴性标记物:CK8/18、CK20、CA125、TTF-1、Villin、CDX-2、Moc31、GCDFP-15、BcA225、 CD34、CR、MC、WT-1
病理诊断:
(右胫骨中段)破碎的肿瘤组织由编织样排列的纤维组织与低立方上皮腺管组织构成,腺样结构多呈簇状分布。符合长骨釉质瘤,伴神经内分泌分化。
长骨釉质瘤
¡ 流行病学:占骨原发肿瘤的0.4%,可发生于3-86岁,中位年龄25-35岁。
¡ 发病部位:多发生于胫骨(近骺端骨干),尤其中下1/3处,占85%-90%。近10%伴有同侧腓骨的单个或多个病变。偶尔有其他发病部位的报道,如股骨、尺骨、锁骨和肋骨等。
¡ 影像学特点:骨干皮质内境界不清楚的溶骨性改变,以囊性、膨胀性为主,有时多房样呈“肥皂泡样”改变(沿长轴扩展)。病变周围有不同程度的硬化缘。骨皮质可增生、硬化,也可以骨质溶解,呈侵蚀性或浸润性破坏,甚至表现出骨膜反应并软组织肿块及远处转移等恶性特征。
¡ 经典釉质瘤组织病理学:由不同比例的上皮性和骨纤维成分构成。按上皮细胞形态分4型
Ø 基底细胞样
Ø 腺管状
Ø 梭形细胞型
Ø 鳞状细胞型
¡ 骨性纤维结构不良型釉质瘤 (OFD样釉质瘤)
¡ 免疫组化:纤维组织Vim阳性。上皮细胞同时表达CK、EMA、Vim。(CK7、CK19、CK5/6阳性,CK8/18阴性)
¡ 鉴别诊断:
Ø 转移癌
Ø 纤维结构不良
Ø 骨性纤维结构不良
Ø 滑膜肉瘤
Ø 其他骨内原发性梭形细胞肿瘤
¡ 组织起源:
Ø 上皮起源
Ø 间叶-上皮转化来源
Ø 神经嵴神经管来源
Ø 多分化潜能的干细胞来源
¡ 遗传学特点:染色体数目异常,主要是染色体7、8、12和19的扩增。
¡ 治疗:手术治疗,外科边界要广泛切除,对放、化疗不敏感。
¡ 预后:低度恶性,非根治手术易复发。可转移
¡ 影响预后因素:性别、年龄、病程、初诊时的症状、肿瘤的鳞状细胞分化及上皮与纤维间质的比例等。
谢谢楼主,很好的病例,学习!有影像学片子吗?